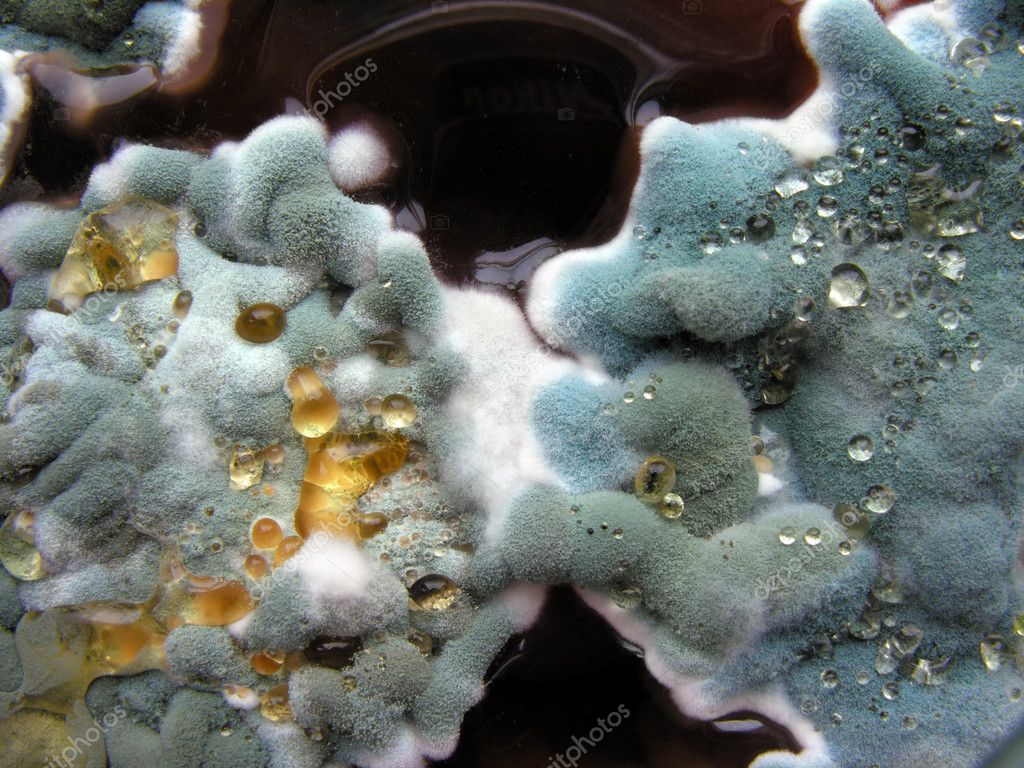
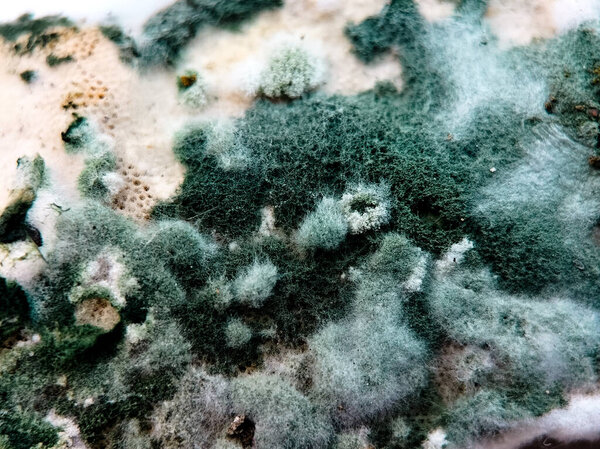
Макроснимок зеленой и белой плесени, растущей на органической поверхности.

- /
- Поиск /
- крупным планом колоний плесени
крупным планом колоний плесени
Колонии плесени, растущие на старой соляной поверхности
image
image
Feb.21, 2016 17:56:41
5.04
0.75
375x500
750x1000
1500x2000
1944x2592
1944x2592
7
1
york010
ФОН МАКРО КРУПНЫЙ ПЛАН РОСТ АБСТРАГИРУЯСЬ ЗАВОД ЖИЗНЬ ОПАСНОСТЬ ГРИБ БИОЛОГИЧЕСКИЕ ТОКСИЧНЫЕ ВЕЩЕСТВА ОРГАНИЧЕСКИЕ БОЛЕЗНИ НЕЗДОРОВЫЕ ЭКОЛОГИЧЕСКАЯ РАЗНОЦВЕТНЫЕ ФЕТТЕЛЬ БИОЛОГИЯ ЛАБОРАТОРИЯ НАУКА БЕЗОПАСНОСТЬ ГРИБЫ РАСПРОСТРАНЕНИЕ МИКРООРГАНИЗМЫ МИКРОБ ОРГАНИЗМ SPORE ГНИЛОЙ РАЗМНОЖЕНИЕ БАКТЕРИИ ФОРМА МИКРОБИОЛОГИЯ АЛЛЕРГИЯ САНИТАРИЯ ИНФЕКЦИЯ ПЛЕСЕНЬ КОЛОНИИ ПРОЛИФЕРАЦИЯ РЕПЛИКАЦИИ МИЦЕЛИЯ